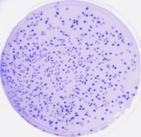

美國(guó)KODAK 公司2007年被onex公司成功收購(gòu)后,成立一個(gè)獨(dú)立的國(guó)際公司-----Carestream Health, Inc,它為全球客戶提供完整系列的醫(yī)療和牙科成像系統(tǒng)以及信息技術(shù)解決方案,分子成像系統(tǒng)和無(wú)損傷檢測(cè)產(chǎn)品。在2006年 Carestream Health, Inc(原柯達(dá))的營(yíng)銷額就達(dá)到25億美元,全世界擁有20000多個(gè)分子成像系統(tǒng)的忠實(shí)客戶,是第一家具備光學(xué)和數(shù)字X線成像功能的多模式分子成像系統(tǒng)供應(yīng)商。
香港自然基因生命科學(xué)有限公司(NatureGene LifeSciences Company Limited )是專業(yè)銷售進(jìn)口生命科學(xué)實(shí)驗(yàn)室儀器的公司,在亞太市場(chǎng)擁有廣泛的市場(chǎng)和客戶,為不同領(lǐng)域的客戶提供醫(yī)療診斷分析儀器、生命科學(xué)領(lǐng)域方面的科研分析儀器及試劑耗材等等。
香港自然生命科學(xué)有限公司為感謝各位新老用戶對(duì)我公司的大力支持,6月1日至9月30日期間推出柯達(dá)凝膠成像系統(tǒng)中新成員GL212 Pro的促銷活動(dòng),本著最大程度讓利的原則,每臺(tái)產(chǎn)品都將給予您想像不到的低價(jià)和高質(zhì)量服務(wù),并隨機(jī)贈(zèng)送核酸熒光染料若干,歡迎各位新老用戶來(lái)電及郵件聯(lián)系。歡迎各位新老用戶來(lái)電及郵件聯(lián)系。
GL212 Pro---全自動(dòng)變焦凝膠成像系統(tǒng)
EB 染色 考馬斯亮藍(lán)染色 染色菌落計(jì)數(shù)
GL212 Pro主要特點(diǎn):
1、 全自動(dòng)6倍變焦鏡頭,f1.2,8-48mm;
2、 高靈敏度CCD,145萬(wàn)像素,使光敏比同類產(chǎn)品高出30%;
3、靈敏度高,可測(cè)出低到10pg的核酸;
4、可測(cè)樣品大小范圍寬:4.5x3.5cm-25x33cm;
5、反射白光燈,紫外透射儀,306nm, 有UV自動(dòng)關(guān)閉功能,LED透射白光燈箱,光強(qiáng)更亮;
6、一機(jī)兩套軟件贈(zèng)送;
7、 具有動(dòng)態(tài)整合.畫(huà)面積分、自動(dòng)曝光和芯片迭加四種圖象攝取方式。
GL212 Pro主要應(yīng)用
配有干涉濾光片,可進(jìn)行包括:
EB,SYPRO橙染色的DNA/RNA的膠
考馬斯亮藍(lán)或銀染色的蛋白膠
不透明膜、96孔板或菌落計(jì)數(shù)板等等
香港自然基因生命科學(xué)有限公司
www.naturegenesci.com
地址:北京市海淀區(qū)西直門北大街41號(hào),天兆家園1E1102室,100044
電話:010-62257793/62259284
傳真:010-62254835-109